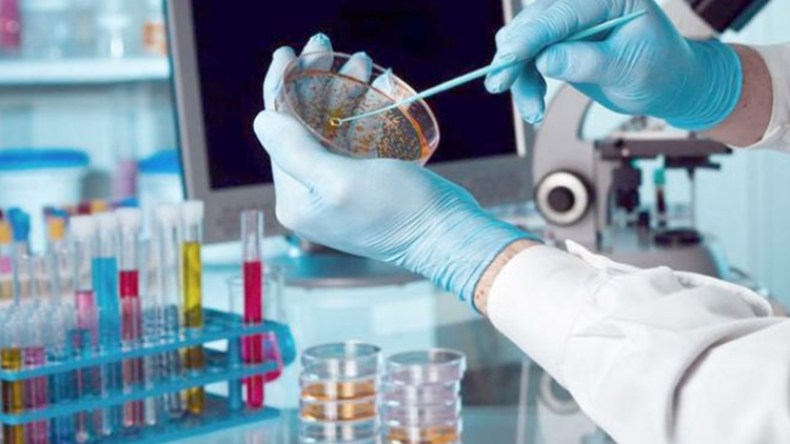

مخابر البحث العلمي: ما لها وما عليها!!
قررت المديرية العامة للبحث العلمي مؤخرا غلق 72 مخبر بحث وإيقاف تمويلها لأنها قدمت “حصيلة سلبس”. وكانت المديرية قد وضعت مقاييس تقييم عامة لتصنيف المخابر وتحديد الناجحة منها وتلك التي ينبغي أن تغلق.
البداية مع بداية القرن
من المعلوم أن مخابر البحث في مؤسساتنا الجامعية قد رأت النور في مطلع هذا القرن. ويبلغ عددها الآن حسب ما صرح به وزير التعليم العالي 1400 مخبر. ويتمّ دوريا تقييم إنجازات هذه المخابر، وتبعا لذلك أُغلق خلال السنوات الثلاث الماضية نحو 100 مخبر. وهذا ليس “حدثا” يستحق الإشادة أو الإدانة لأن غلق مخابر وفتح أخرى أمر طبيعي يأتي منطقيا نتيجة التقييم.
من جهة أخرى، فإن من عادتنا جميعا التباهي بالعدد بينما التباهي الحقيقي ينبغي أن يركز على النوعية والإنجازات. فمن حقّ وزارة التعليم العالي أن تأمر –كما فعلت بلدان غربية- المخابر التابعة لنفس المؤسسة أو المنطقة بالتجمّع في مخابر موحدة فيصبح عدد هذه الهيئات 500 بدل 1400 مخبر !أو على العكس من ذلك، يمكن أن تضع الوزارة قانونا يدعم التكاثر فيتجاوز عدد المخابر بين عشية وضحاها 2000 مخبر.
في مطلع هذا القرن راسلت وزارة التعليم العالي الجامعات داعيةً سلك الأساتذة إلى فتح مخابر للبحث مموَّلةً من قِبَل الدولة وذلك بهدف تحفيز البحث العلمي في الجامعات. نتذكّر في ذلك الوقت أن بعض الزملاء – ولم يكونوا من صغار السن- انفجروا ضحكًا عندما اطلعوا على دعوة الوزارة! لماذا؟ لأنهم لم يكونوا يعلمون أن الجامعات يمكن أن تضم مراكز بحث في كل العلوم يطلق عليها اسم مخبر! فالمخبر في أذهان هؤلاء كان هو المكان الذي تجرى فيه التحاليل الطبية والكيميائية لا غير، ورفضوا تجسيد ما سعت إليه الوزارة.
أما الآن فسلْ أي أستاذ وأي طالب في الدراسات العليا وستجده ملمًا بدور مخابر البحث في كل الاختصاصات. وهذا يعتبر تطوّرا مهمّا في ذهنيات الجامعيين أدى إلى فتح مخابر بحث في كل مدينة جامعية، بما فيها مدن إليزي وتندوف والطارف والنعامة والبيّض… وفي العاصمة وحدها ناهز عددها 250 مخبر. كل ذلك لتلبية متطلبات نحو 37 ألف أستاذ باحث وطلاب الدراسات العليا.
وقد أزعجنا في المدة الأخيرة حوار مطوّل في إحدى القنوات الخاصة حيث كان المنشط وبعض مرافقيه يؤكدون أن كل مخبر تحصل على ملياريْ سنتيم، وأن المخابر التي أغلقت لا بد أن يُحاسب أصحابها على تبذير 144 مليار سنتيم!! وكأن الأمر يتعلق باختلاس مثل هذا المبلغ من خزينة بنك، بل أشار أحدهم إلى أن بعض هذه الأموال صرفت في السفريات السياحية باسم طلب العلم!
والمقام هنا ليس لاستعراض القوانين التي تسيّر المخابر ولا لنكران وجود تجاوزات من قبل مسيّري المخابر… دون أن ننسى بأن الآمر بالصرف هو في كل الأحوال مدير المؤسسة وليس مسؤول المخبر. لكننا نستطيع الإشارة إلى عدة جوانب تبيّن أن التجاوزات -وإن حدثت- ليست كما قد يتصوّرها القارئ.
لعلنا نقول في البداية بأننا لسنا متأكدين من أن كل المخابر تحصلت على ملياريْ سنتيم خلال وجودها. ثم إن الجزء الأكبر من التمويلات تذهب للتجهيز المختلف الأشكال (من الطاولات والكراسي ولوازم المكاتب إلى التوثيق والأجهزة الإلكترونية والآليات اللازمة لتخصص المخبر). والمنتسب للمخبر لا يتقاضى أي أجر أو علاوة، ولا يحظى بأي تكفّل مادي من المخبر عند التنقل إلى الخارج للمشاركة في المؤتمرات أو لإجراء تجارب في جامعات أجنبية يعتذر عليه القيام بها في جامعته. وأقصى ما يمكن الحصول عليه هو تذكرة طائرة إن توفرت الأموال.
الحاضنة الفعلية
في الواقع، ينبغي ملاحظة أن الأموال التي تستخدمها المخابر تساعد الجامعة التي تؤويها لأن مسؤولي المؤسسة غالبا ما يرفضون الطلبات الآتية من هيئة التدريس المنتسبة لمخابر البحث بحجة أن المخبر كفيل بذلك… وكثيرا ما يحدث توتر في العلاقات بسبب هذه النقطة. أخيرا، ننبّه إلى أن في حال توقف عمل المخبر فكل ممتلكاته تعود تلقائيا إلى الجامعة التي تؤويه.
لا بد أن نعرف أن أكبر عمل تقدّمه مخابر البحث هو أنها تعتبر في كل جامعاتنا الحاضنة الفعلية لطلبة الدراسات العليا. ففيها يتم إعداد مشاريع البحث وبرامج الماستر والدكتوراه، وفي مرافقها تجرى التجارب وتُنجز المشاريع. أما الإبداع الجاد ونشر الأبحاث وإنجازها فلعلها تأتي عندنا في المحل الثاني أو الثالث. وهذا هو واقع الحال في الوقت الراهن. وليس من حقنا أن نستهين بدور المخابر ولا أن نضخم منجزاتها.
ومن سلبيات القوانين التي تحكم المخابر أنها لا تسهّل أبدا زيارة الباحثين الأجانب. فقضية غلاء التذاكر عبر الخطوط الجوية الجزائرية مثلا، غالبا ما تطرح بشكل ملحّ منذ عقود لأنها تستنزف ميزانية المخبر والمؤسسة. ثم إن الباحث الأجنبي عندما يأتي إلى الجزائر فإننا لا نقدم إليه سوى المبيت في الفندق والإطعام. ولا يُدفع له دينار واحد! فلو أراد تناول قهوة أو ركوب طاكسي فعليه أن يدفع الثمن بنفسه! وهذا منطق لا يقبله عاقل ولا يشجع الأجنبي على التعاون معنا!!
وتوضيحا لهذا الوضع نسرد المثال التالي: فقد استضاف مخبرنا (مخبر المعادلات التفاضلية الجزئية-القبة) خلال الشهرين الماضيين 5 أساتذة أوروبيين، أتوا في فترات متوالية لمدة أسبوع، عدا واحد قضى يومين كمشرف على طالب ناقش رسالته. أما الأربعة الآخرون فكانوا يأتون صباحا بين الثامنة والتاسعة ويظلون يعملون إلى ما بعد السادسة مساء مع طلاب الدكتوراه من أعضاء المخبر، وكذا مع بعض الزملاء.
بل منهم من قدِم إلى المخبر حتى يوم الجمعة لاستكمال أعمال مع الطلبة والزملاء قبل سفره! ومن يقوم يوميا بنقل هؤلاء الزوار من وإلى الفندق، ومن وإلى المطعم؟ هم الزملاء أعضاء المخبر بوسائلهم الخاصة. لقد قُدّر ما صَرف هؤلاء من أموالهم الخاصة في سبيل السير الحسن لإقامة هؤلاء الزوار نحو 5 ملايين سنتيم. هذا دون أن ننسى الوقت الذي قضوه في أداء هذه المهام.
لذلك نتصوّر أنه لو تقوم الوزارة بتقييم عدد الزوار الأجانب للمخابر لوجدته في تناقص لأن هذا الأمر أصبح لا يطاق… لا يطاق بسبب بعض القوانين العرجاء التي تحكم المخابر والمؤسسات الجامعية! وما مشكل الزوار، في آخر المطاف، سوى واحد من المشاكل التي تقف حجر عثرة أمام تطوّر البحث العلمي عندنا. فمتى ستعالج الوزارة هذا الوضع؟!!














